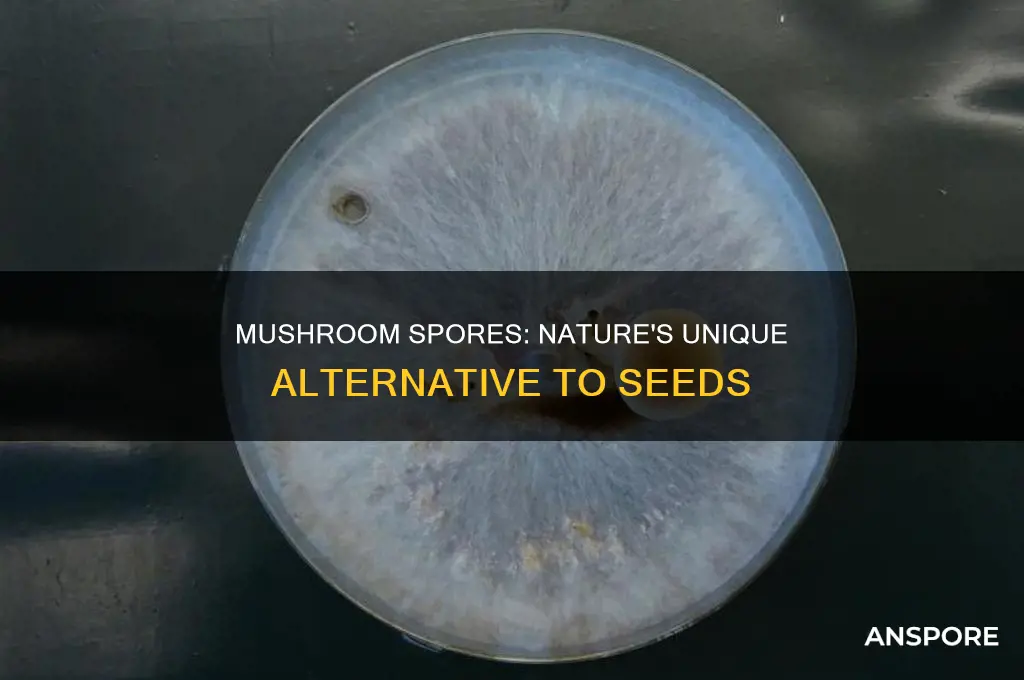
how are mushroom spores different from seeds

Mushrooms are a type of fungus, and like other fungi, they reproduce by producing spores. Spores are a unit of sexual or asexual reproduction that may be adapted for dispersal and survival in harsh conditions. They are single-celled organisms with a solid cell wall that allows them to survive extreme conditions. In contrast, seeds are multicellular structures that are produced by flowering plants and contain stored food resources, enabling them to germinate in harsher conditions than spores.
| Characteristics | Values |
|---|---|
| Structure | Spores are single-celled organisms with a solid cell wall. Seeds are multicellular structures differentiated into several parts: seed coat, embryo, and endosperm. |
| Reproductive Function | Spores are units of asexual reproduction. Some fungi also sexually reproduce by spores. Seeds are units of sexual reproduction. |
| Food Reserves | Spores do not contain stored food resources. Seeds contain stored food in their endosperm, enabling them to germinate in harsh conditions. |
| Germination Conditions | Spores require more favorable conditions for germination. Seeds can germinate in harsh conditions. |
| Dispersal | Spores are dispersed by wind, ensuring long-distance travel. Seeds are found inside fruits. |
| Predation | Spores are less subject to animal predation but more susceptible to fungal and bacterial predation. Seeds are protected by a seed coat from dehydration and animal predation. |
| Development | Spores give rise to haploid gametophytes upon germination. Seeds produce a developing embryo (multicellular sporophyte) upon germination. |
Explore related products
What You'll Learn
- Spores are produced by non-flowering plants and fungi, seeds are produced by flowering plants
- Spores are haploid and unicellular, seeds are multicellular and diploid
- Spores do not contain stored food resources, seeds do
- Spores are more resilient to harsh conditions than seeds
- Spores are usually microscopic, seeds are not

Spores are produced by non-flowering plants and fungi, seeds are produced by flowering plants
In biology, spores are units of sexual (in fungi) or asexual reproduction. They are produced by non-flowering plants and fungi. In plants, spores are usually haploid and unicellular and are produced by meiosis in the sporangium of a diploid sporophyte. They are found in the underside of the leaves of ferns and mosses, as well as the gills of fungi.
Plants that are homosporous produce spores of the same size and type. Heterosporous plants, such as seed plants, spikemosses, quillworts, and ferns of the order Salviniales, produce spores of two different sizes: the larger spore (megaspore) functions as a "female" spore, and the smaller (microspore) functions as a "male" spore.
On the other hand, seeds are produced by flowering plants and are units of sexual reproduction. Seeds are developed from fertilized ovules after pollination. They are multicellular structures differentiated into several parts: a seed coat, an embryo, and an endosperm. The seed coat is a protective layer that shields the seed from dehydration and predation. The endosperm stores the required nutrients for the embryo's development.
The main difference between spores and seeds is that spores do not contain stored food resources and require more favourable conditions for germination. In contrast, seeds contain stored food in their endosperm, enabling them to germinate in harsher conditions.
Sterilizing Mushroom Substrate: Techniques for Success
You may want to see also

Spores are haploid and unicellular, seeds are multicellular and diploid
In biology, spores and seeds are both units of reproduction in organisms. However, spores are haploid and unicellular, while seeds are multicellular and diploid. This fundamental difference sets the groundwork for several other distinctions between spores and seeds.
Spore-forming organisms include certain plants, algae, fungi, and protozoa. Spores are typically haploid, meaning they contain half the number of chromosomes required for the formation of a complete organism. In plants, spores are often produced by non-flowering species through meiosis in the sporangium of a diploid sporophyte. Ferns and mosses are common examples of spore-bearing plants. The produced spores are usually microscopic, single-celled structures that carry the genetic material to new locations. These spores can develop into male and female germ cells, giving rise to miniature free-living haploid plants (prothalli) that produce gametes for the restoration of diploidy.
On the other hand, seeds are multicellular structures produced by flowering plants through sexual reproduction. Seeds are diploid, containing a full set of chromosomes resulting from the fusion of male and female gametes. The development of seeds involves mitosis, giving rise to distinct parts: the seed coat, embryo, and endosperm. The seed coat protects the seed from dehydration and predation, while the endosperm provides essential nutrients for the embryo's development. This enables seeds to survive and germinate in harsh conditions, in contrast to spores which require more favourable conditions.
The structural and genetic differences between spores and seeds are key factors in understanding their respective reproductive strategies. While spores are simpler, unicellular dispersal units, seeds are more complex, multicellular entities that house the developing embryo of the next generation.
Mushrooms: Healthy Raw or Cooked?
You may want to see also

Spores do not contain stored food resources, seeds do
The main difference between spores and seeds is that spores do not contain stored food resources, whereas seeds do. This means that spores require more favourable conditions for germination, while seeds are capable of surviving and germinating in harsher conditions.
Spores are the units of asexual reproduction in organisms, and they are haploid and unicellular. They are often microscopic and single-celled, with a solid cell wall. Their purpose is to spread an organism's genetic material to new locations. In the case of spore-shedding vascular plants, wind distribution of very light spores provides a great capacity for dispersal. Spores are also less likely to be eaten by animals than seeds. However, spores are more susceptible to fungal and bacterial predation.
Seeds, on the other hand, are the units of sexual reproduction, and they are multicellular and diploid. They are developed by mitosis from ovules with fertilized egg cells. Seeds contain a developing embryo, produced by the fusion of the male gamete of the pollen tube with the female gamete formed within the ovule. The seed coat protects the seed from dehydration and predation, while the endosperm stores the required nutrients for the embryo's development.
In the context of mushrooms, spores are produced by fungi during sexual and asexual reproduction. The caps and stems of mushrooms are just the fruiting bodies of the fungi, and the spores are found underneath the caps. Mushrooms have the potential to produce a vast number of spores, which are released and carried by wind currents. When spores land in a moist place, they germinate and grow into a network of fine threads called hyphae, which digest food for the growing fungus.
Mushrooms and Sex: A Stimulating Combination?
You may want to see also
Explore related products

Spores are more resilient to harsh conditions than seeds
While spores and seeds are both reproductive structures of plants, spores are more resilient to harsh conditions than seeds. Spores are haploid and unicellular, while seeds are diploid and multicellular. Seeds are differentiated into several parts: the seed coat, embryo, and endosperm. The seed coat protects the seed from dehydration and predation. The endosperm stores the required nutrients for the embryo's development.
Spores, on the other hand, are protected by a hard cell wall. They do not contain stored food resources, which makes them less prone to animal predation. However, they are more susceptible to fungal and bacterial predation. Their main advantage is that they require the least energy and materials to produce.
The ability of spores to survive harsh conditions is also reflected in their role as resistance structures for bacteria. Bacterial spores contain genomic DNA surrounded by a thick cell wall, enabling bacteria to survive under unfavorable conditions.
Additionally, spore-bearing vascular plants, such as ferns, have a greater capacity for dispersal due to the light weight of their spores, which can be easily distributed by the wind. This dispersal capability further contributes to the resilience of spores by allowing them to adapt to different environments.
Delicious Coastal Seafood-Stuffed Mushrooms: A Tasty Treat
You may want to see also

Spores are usually microscopic, seeds are not
In biology, spores are units of sexual (in fungi) or asexual reproduction. They are usually microscopic, single-celled structures whose only purpose is to spread the organism's genetic material to new locations. Spores are haploid and unicellular, and they are often adapted for dispersal and survival in harsh conditions. They are produced by non-flowering plants and fungi.
On the other hand, seeds are multicellular structures that are developed by mitosis from ovules with fertilized egg cells. They are units of sexual reproduction and are produced by flowering plants. Seeds are larger than spores and are visible to the naked eye. They are diploid and multicellular, and they are differentiated into several parts: the seed coat, embryo, and endosperm. The seed coat protects the seed from dehydration and predation, while the endosperm stores the required nutrients for the embryo's development.
The main difference between spores and seeds as dispersal units is that spores are unicellular, while seeds contain a developing embryo within them. Spores are the first cell of a gametophyte, while seeds are multicellular sporophytes of the next generation. Seeds are larger and more complex than spores, and they contain stored food resources, enabling them to germinate in harsh conditions.
While spores are usually microscopic, seeds are not. Seeds are larger structures that can be seen without magnification. They are multicellular and contain a developing embryo, which gives them the ability to survive and grow under various conditions. In contrast, spores are single-celled and require more favourable conditions for germination as they do not contain stored food reserves.
The Ultimate Guide to Spraying Mushrooms While Away
You may want to see also
Frequently asked questions
The main difference is that spores are unicellular and haploid, whereas seeds are multicellular and diploid. This means that spores do not contain stored food resources and require favourable conditions for germination, while seeds are capable of surviving under harsh conditions.
The main function of mushroom spores is to spread to new locations in search of food and a mate, ensuring the mushroom's survival while also possibly creating new strains.
Mushroom spores are found on the gills of fungi. They are usually microscopic and single-celled structures, whose only purpose is to spread the mushroom's genetic material to new locations.

























